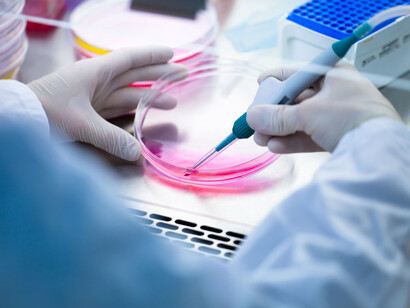
La ricerca scientifica in Italia

Impossibile sottrarsi al rito che accompagna ogni passaggio d'anno, interrogandosi sul cosa ci riserva l'anno che verrà. Ma non per fare previsioni - a volte sin troppo facili, altre troppo ardue - quanto piuttosto per esprimere auspici. Siamo, almeno ancora... , un paese ricco di potenzialità. Anche se troppo spesso sembriamo incapaci di trasformarle in realtà. Forse perché abbiamo smarrito la capacità di pensarci come collettività, e quindi di mettere mano - insieme - a quelle cose che trascendono la possibilità del singolo.
Il primo auspicio, dunque, è che il nuovo anno ci veda recuperare questa capacità, ci restituisca un sentire comune, di cui si avverte un gran bisogno. In fondo, la nostra storia è piena di scatti d'orgoglio, d'improvvisi risvegli della coscienza collettiva. E a ben vedere, non perdiamo mai un tessuto connettivo che li rende possibili, laddove se ne diano le condizioni storiche, e si manifesti quel quid soggettivo che vi faccia da detonatore. Non si tratta di evocare un volemose bene trasversale, che nasconda sotto il tappeto le differenze, anche radicali, siano esse politiche, culturali, sociali e/o economiche. Quanto piuttosto di recuperare consapevolezza che, al di là di queste, l'essere diventati un paese diseguale, è in realtà un palla al piede per tutti. Troppa diseguaglianza economica, all'interno del paese, e troppa diseguaglianza (sociale, civile, tecnologica... ) tra il nostro paese e gli altri. E nessuno si salva da solo.
Il secondo auspicio, ma in fondo propedeutico al primo, è che si riesca - almeno in parte, ché i guasti sembrano ahimé assai profondi e radicati... - ad uscire da una spirale di avvitamento triviale, in cui l'insulto, l'invettiva personale, il dispregio, sembrano aver definitivamente preso il posto del confronto, anche aspro, sulle cose. Paradossalmente, l'involgarimento della vita civile e politica, procede parallelo con il suo appiattirsi. Quanto più vaghe e sottili si fanno le differenze, sul piano sostanziale, tanto più si inasprisce il linguaggio con cui viene messo in scena il confronto. Ma le parole sono pietre, e anche se vengono scagliate con veemenza soltanto per coprire la comune resa a un pensiero unico, stanno avvelenando la società. Torniamo a scontrarci, duramente, sulle questioni reali, e dimettiamo la volgarità come sostitutivo della capacità di farlo.
Il terzo auspicio riguarda la nostra capacità di guardare gli altri. Non in senso individuale, stavolta, ma proprio come collettività. Cambiare il nostro sguardo nei confronti dell'Europa, per un verso, e quello nei confronti dei migranti che, soprattutto attraverso il nostro paese, vi cercano nuove speranze di vita. Sono in realtà due questioni assai connesse tra loro, perché entrambe ci interrogano su ciò che saremo. Ogni sguardo che si anima di diffidenza, di ostilità, di chiusura, è innanzitutto miope. È lo sguardo dello struzzo, che per paura di ciò che vede nasconde la testa sotto la sabbia. Non c'è dubbio che al crocevia tra Europa economica e migrazioni (e noi vi siamo anche geograficamente!), si producano squilibri, e che questi possano costituire un pericolo. Ma affrontarli con paura, illudersi di poter eludere il corso degli eventi, o di fermarlo erigendo muri, in realtà non fa che rendere questa possibilità più concreta. Soffiare sul fuoco della paura, farà divampare l'incendio. Ciò di cui necessitiamo, è più apertura, maggiore integrazione. In Europa, e tra l'Europa e chi vi giunge. Perché i pericoli diventino opportunità. Nessuno dovrebbe saperlo meglio di noi, che abbiamo alle spalle una storia di straordinaria ricchezza, proprio perché è stata una storia di innumerevoli integrazioni etniche e culturali.
Il quarto auspicio, è che torniamo a scoprire la bellezza. Soffocati come siamo da un bombardamento di orrori e volgarità, sembriamo incapaci di vedere la bellezza, di riconoscerla, di riconoscerne il valore. Tornare a vederla, significa innanzitutto tornare a desiderarla. Ma non come pio desiderio, come astrazione; ma come elemento concreto del nostro agire quotidiano. Come un diritto, da rivendicare con forza e determinazione.
Il quinto auspicio è che si torni al rispetto della Terra. Siamo un paese orograficamente particolare, che richiede una cura adeguata, e che invece abbiamo allegramente saccheggiato, devastato, con l'incoscienza predatoria (talvolta anche inconsapevole) di chi non sa guardare che a se stesso e all'oggi. Recuperare uno sguardo lungo, capace di abbracciare gli altri e il futuro, significa anche capire l'urgenza di declinare diversamente il nostro rapporto col territorio. Averne comprensione e rispetto, è una delle chiavi per un domani migliore.
Il sesto auspicio, è che le differenze di genere tornino ad essere una possibilità di arricchimento reciproco, non un limes conflittuale. Che si comprenda che un diritto è la possibilità per ciascuno di fare liberamente ciò che ritiene meglio per sé, e che se a qualcuno non piace è suo diritto non farlo, o fare diversamente, ma non negare ad altri questa possibilità. E il primo di questi diritti, davvero inalienabile, è di scegliere chi amare. Non ostracizzare chi vuole amare qualcuno dello stesso sesso, e ancor meno uccidere chi vuole amare qualcun altro.
Il settimo auspicio, è che torniamo a sperare; non per morirne, ma per farne spinta verso il futuro. Siamo un paese che invecchia, e anche un po' male... , e questo non fa che alimentare tutte le spinte negative, conservatrici, che nel futuro vedono un'incognita se non una minaccia. Al tempo stesso, siamo un paese in cui non si sa invecchiare, in cui ci si illude d'una eterna giovinezza, mantenuta grazie all'immobilità. Il lavoro - sia esso la prevalente occupazione del tempo, o la possibilità di esercitare il potere - troppo spesso appare come l'unica ragione di vita. Abbiamo bisogno di recuperare consapevolezza che le diverse stagioni della vita, possono avere diverse ragioni di vita. E che arriva un tempo in cui è bene (e bello) farsi da parte, lasciare il passo ad altri e fare altro. Così come, d'altra parte, che non serve lamentarsi se non ti lasciano spazio, ma che occorre saperselo prendere.
L'ottavo auspicio, è che usciamo da ogni guerra. Non sempre la guerra è evitabile, e non sempre è - quindi - ingiusta. Ma non ce n'è una, di quelle a cui oggi in un modo o nell'altro partecipiamo, che non lo sia. E nella cui genesi (e nel cui prosieguo) non abbiamo la nostra parte di responsabilità. Uscirne, quindi, con un gesto unilaterale, non sarebbe soltanto un modo per chiamarsi fuori, ma al contrario sarebbe la forma (politicamente) più alta per esserci dentro. Per dire che non può essere questa la chiave per risolvere i conflitti. In fondo, abbiamo scritto nella Costituzione che ripudiamo la guerra "come mezzo di risoluzione delle controversie internazionali".
L'ultimo auspicio, infine, è che - avendo appena ieri detto a grande maggioranza che la nostra Costituzione ci piace, così com'è - ci impegnassimo un po' tutti affinché venisse attuata davvero, in tutto e per tutto. Cominciando da quel famoso art. 9, così citato nei discorsi e così bistrattato nei fatti. E che, in sole 24 parole, dice in realtà tantissimo. "La Repubblica promuove lo sviluppo della cultura e la ricerca scientifica e tecnica. Tutela il paesaggio e il patrimonio storico e artistico della Nazione".